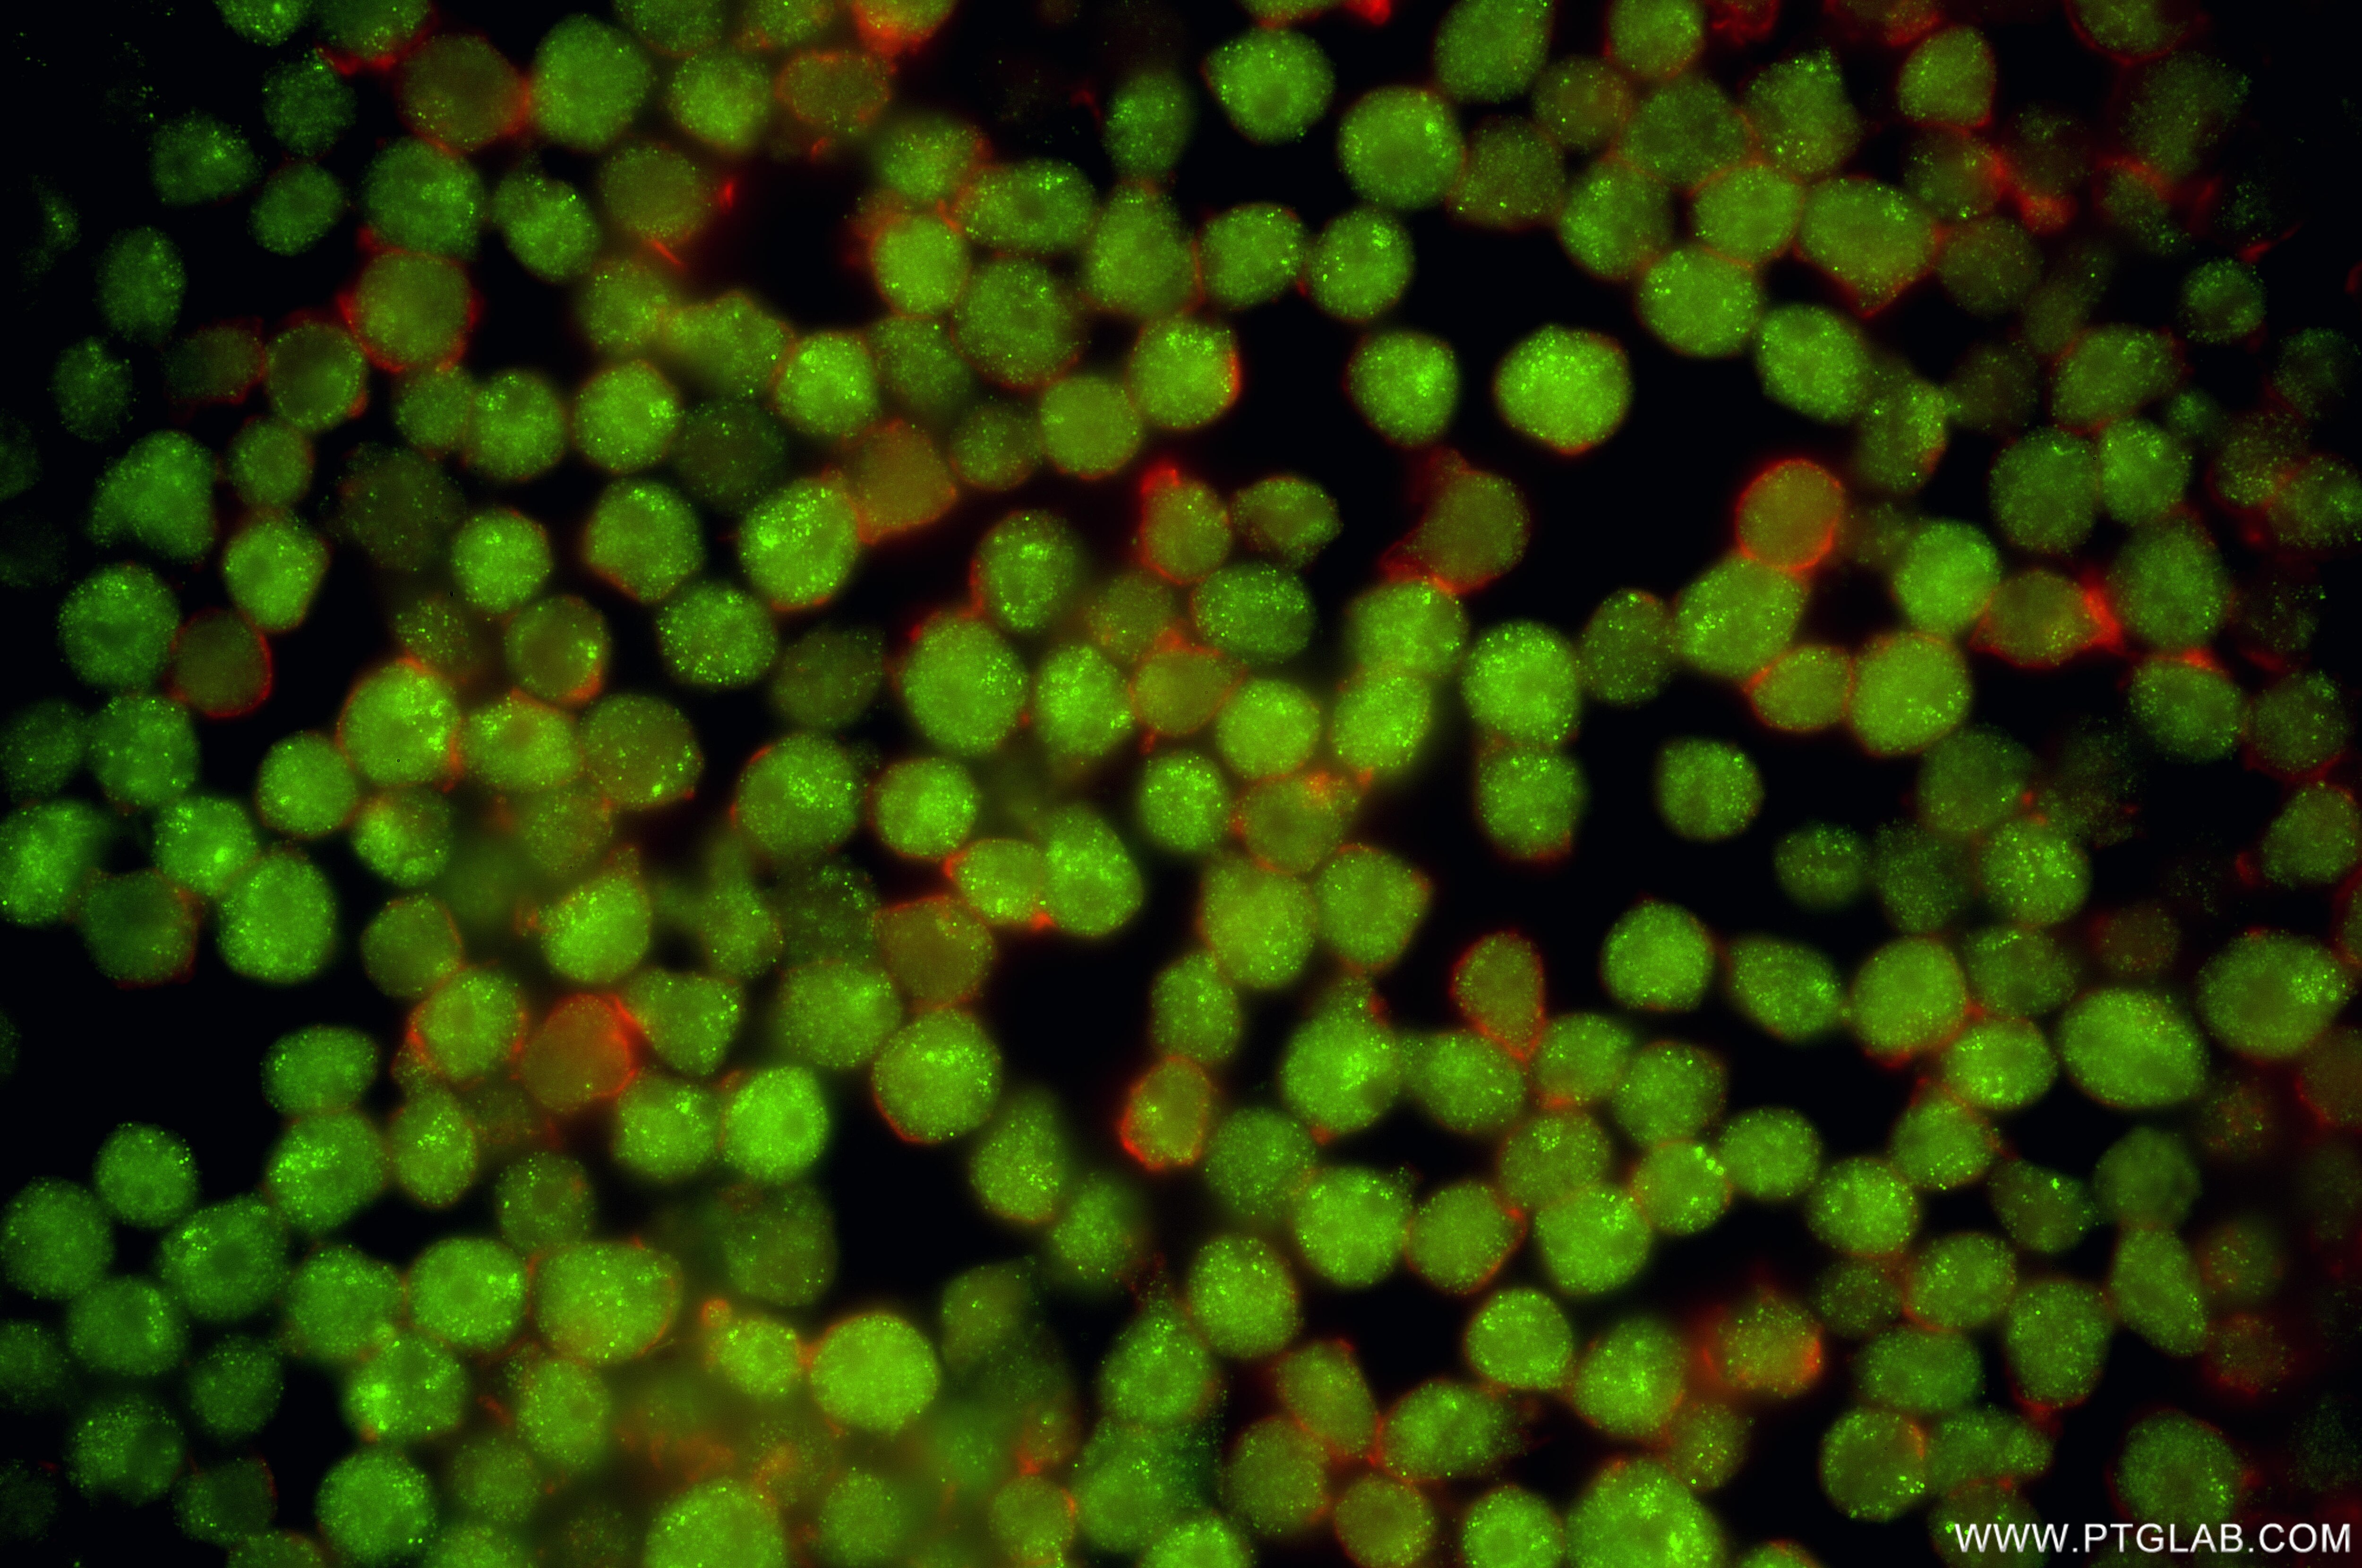
Immunofluorescence (IF) / fluorescent staining of Jurkat cells using FOXP1 Recombinant monoclonal antibody (86937-1-RR)

Product Information
86937-1-PBS targets FOXP1 as part of a matched antibody pair:
MP02841-1: 86937-2-PBS capture and 86937-1-PBS detection (validated in Sandwich ELISA)
Unconjugated rabbit recombinant monoclonal antibody in PBS only (BSA and azide free) storage buffer at a concentration of 1 mg/mL, ready for conjugation. Created using Proteintech’s proprietary in-house recombinant technology. Recombinant production enables unrivalled batch-to-batch consistency, easy scale-up, and future security of supply.
This conjugation ready format makes antibodies ideal for use in many applications including: ELISAs, multiplex assays requiring matched pairs, mass cytometry, and multiplex imaging applications.Antibody use should be optimized by the end user for each application and assay.
| Tested Reactivity | human |
| Host / Isotype | Rabbit / IgG |
| Class | Recombinant |
| Type | Antibody |
| Immunogen |
CatNo: Ag17045 Product name: Recombinant human FOXP1 protein Source: e coli.-derived, PGEX-4T Tag: GST Domain: 349-457 aa of BC131720 Sequence: QLELQLAKDKERLQAMMTHLHVKSTEPKAAPQPLNLVSSVTLSKSASEASPQSLPHTPTTPTAPLTPVTQGPSVITTTSMHTVGPIRRRYSDKYNVPISSADIAQNQEF Predict reactive species |
| Full Name | forkhead box P1 |
| Calculated Molecular Weight | 677 aa, 75 kDa |
| Observed Molecular Weight | 75-77 kDa, 65-67 kDa |
| GenBank Accession Number | BC131720 |
| Gene Symbol | FOXP1 |
| Gene ID (NCBI) | 27086 |
| Conjugate | Unconjugated |
| Form | Liquid |
| Purification Method | Protein A purification |
| UNIPROT ID | Q9H334 |
| Storage Buffer | PBS only, pH 7.3. |
| Storage Conditions | Store at -80°C. |
Background Information
FOXP1, also known as Mac-1-regulated forkhead, is a 677 amino acid protein, which forms homodimers and heterodimers with FOXP2 and FOXP4 (PubMed:25027557). Dimerization is required for DNA-binding. FOXP1 has an important function in neuronal development.9 Mutations of its gene, FOXP1, located on chromosome 3p14.1,7 can result in the development of autism spectrum disorder, intellectual disability, speech and language deficits as well as motor development delay. FOXP1 is also engaged in lung and esophagus morphogenesis, as well as in B-cell development.7,10 The widely researched role of FOXP1 in carcinogenesis is of great importance, although still unclear to some extent. FOXP1 exists some isoforms with MV 75-77 kDa, 65-67 kDa, 12 kDa.